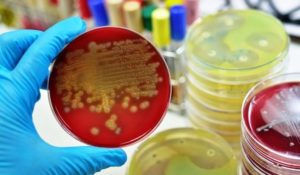
image

Стафилококк в ухе: лечение и симптомы — Сайт о заболеваниях глаз и их лечении

› Болезни уха ›
В нашем организме и на поверхности кожи постоянно находятся бактерии, в том числе и стафилококк. В обычном состоянии эти микроорганизмы не способны причинить нашему здоровью никакого вреда, но при благоприятных для них факторах они начинают активно размножаться и поражать ткани, вызывая воспалительные и патологические процессы.
Лор-органы из-за нежной слизистой и чувствительных покровов чаще других тканей оказываются подвержены атакам активизировавшихся бактерий. Условно-патогенный стафилококк может поразить и разные отделы слухового органа. Какие факторы являются благоприятными для развития данных микроорганизмов? Как диагностировать и лечить стафилококк в ушах?
Причины активизации
Привести к активизации стафилококка может несколько факторов:
- Чаще всего данный тип бактерий активным делает несоблюдение мер личной гигиены. Именно поэтому от стафилококка в ушах чаще всего страдают маленькие дети, у которых поражение проявляется в виде гнойников, болезненных фурункулов и развития гнойного отита.
- Привести к тому, что стафилококк активизируется, может и значительное снижение защитных сил организма. Это состояние, в свою очередь, способно возникнуть из-за дефицита витаминов, длительного применения антибактериальных препаратов, сильных стрессов, переохлаждения, дисбактериоза в кишечнике и даже неправильного питания.
- Развитие патогенной флоры также часто происходит после травмирования поверхности кожи на ушах, во время которого в ткани проникают бактерии.
Вне зависимости от причины, провоцировавшей активность патогенной флоры, стафилококк в ушах будет проявляться специфическими симптомами, обнаружив которые, следует немедленно обратиться к отоларингологу. Своевременная диагностика поражения и его лечение позволит избежать неприятных последствий.
Симптомы активизации стафилококка
Симптоматика поражения тканей органа слуха стафилококком не является специфической, именно поэтому поставить правильный диагноз способен только специалист после тщательного осмотра уха с помощью профессиональных инструментов.
- Поражение тканей патогенной флорой приводит к ее отечности, что значительно влияет на качество звука — пациенты отмечают чувство заложенности и появление шума в ушах.
- Нажатие на козелок приводит к возникновению острой боли.
- Внутри слухового прохода ощущается чувство зуда.
- Из ушного канала начинает выделяться зеленоватая слизь, имеющая яркий неприятный запах. Постепенно экссудат превращается в гной, выходящий из слухового прохода вместе с серой и образующий корочки.
- Пациенты отмечают общую слабость, а при наличии ответной реакции иммунной системы на развитие патогенной флоры — и значительное (до 40 градусов) повышение температуры тела.
При осмотре отоларинголог с помощью отоскопа увидит характерный признак развития патогенной флоры — пораженные ткани окрашиваются в золотистый оттенок. Чаще всего воспаляются ткани наружного отдела уха, но иногда патологический процесс распространяется и на среднее ухо, вызывая гнойный отит.
Почувствовав болезненные ощущения в органе слуха и заметив, что из ушного прохода начали появляться выделения, следует обращаться к специалисту.
Отоларинголог определит природу заболевания и назначит соответствующее лечение. Если пренебречь посещением доктора, развитие патогенных микроорганизмов в тканях уха способно привести к тяжелым последствиям.
Осложнения
Любое заболевание требует профессионального и правильного подхода к лечению. Если не заниматься терапией воспаления, развившегося в тканях слухового органа, патологический процесс может привести к опасным осложнениям.
- Воспалительный процесс, который вызвал золотистый стафилококк в ухе, без лечения может распространиться на соседние ткани — в том числе и на височную кость, вызвав ее поражение (мастоидит);
- поражение тканей наружного уха может продвинуться внутрь и вызвать расплавление барабанной перепонки, что приведет к нарушению функциональности слухового органа;
- если патогенная флора проникнет в средний отдел уха, это может привести к развитию гнойного отита; отсюда стафилококк способен по евстахиевой трубе опуститься в носоглотку и дыхательные пути, вызвав пневмонию;
- поражение патогенной флорой внутреннего отдела уха приведет к необратимой тугоухости, а также способно вызвать воспаление мозговых оболочек;
- выделяемые в процессе жизнедеятельности стафилококка вещества негативно отражаются на составе крови и способны вызвать сепсис.
Чтобы подобных последствий не возникло, важно вовремя обратиться к специалисту и строго следовать его рекомендациям по терапии заболевания.
Особенности диагностики и лечения
Стафилококк — очень сильная бактерия, которая не боится большинства антибиотиков, устойчива к популярным антисептикам и воздействию температур.
Так, ее невозможно убить с помощью спирта и перекиси водорода, последней она даже способна питаться.
Зато стафилококк боится кипячения и анилиновых красителей — поэтому своевременная обработка пореза или микротравмы обычной зеленкой убережет вас и ваших близких от развития воспалений.
Врачи при определении методики терапии основываются на том, где располагается пораженный бактериями участок. Если его обработка не труднодоступна, то специалисты назначают препараты местного действия. При невозможности воздействовать на воспаление (если оно локализовано у барабанной перепонки или в среднем отделе уха) назначается пероральный прием препаратов.
Местное лечение
При поражении стафилококком наружного уха врач рекомендует вам ежедневно проводить комплексные терапевтические мероприятия:
- Обработка пораженного участка мазями с поликсином, колистином или неомицином;
- использование гентамициновой мази;
- применение капель с кортикостероидами;
- использование жаропонижающих препаратов и обезболивающих капель для снятия неприятной симптоматики.
Чтобы лечение принесло скорейший результат, обработку пораженного участка следует производить около 4 раз в сутки через равные промежутки времени.
Общая терапия
При развитии патогенной флоры за барабанной перепонкой отоларинголог назначит вам сильный антибактериальный курс длительностью 10 дней, подобрав препараты и дозировку исходя из восприимчивости обнаруженных бактерий, вызывавших воспаление.
Если применение антибиотиков не останавливает воспалительный процесс и скопление гноя усиливает болезненность заболевания, специалисты принимают решение о необходимости проведения тимпанопункции или шунтирования барабанной перепонки для обеспечения выхода гнойным массам. Выделения отправляются в лабораторию, где с помощью посева определяется, какими препаратами можно побороть данный штамм стафилококка.
Профилактические меры
Любую болезнь легче предупредить, чем лечить. Чтобы не заниматься длительной терапией опасного воспаления в важном органе, лучше следовать мерам профилактики и не допускать активизации стафилококка.
- Укрепляйте иммунитет, и тогда защитные силы организма не позволят бактериям проснуться;
- придерживайтесь здорового питания и пропивайте курсы поливитаминов;
- соблюдайте меры гигиены, своевременно очищая слуховой проход и ушные раковины от скопившейся грязи и пыли;
- защищайте уши от переохлаждения в холодную погоду.
Стафилококк в ушах: причины, симптомы и лечение Ссылка на основную публикацию
Стафилококк в ушах: симптомы и особенности лечения
В окружающей среде и человеческом организме присутствуют множество бактерий, некоторые из которых являются безвредными для здоровья человека. Но существуют микроорганизмы, способные нанести большой вред и одним из таких представителей считается золотистый стафилококк. Этот микроб поражает слуховой орган и вызывает развитие опасных заболеваний.
Что представляет собой золотистый стафилококк и причины его возникновения
К наиболее опасному виду бактерий относят золотистый стафилококк, который способен вызывать воспалительные процессы в ушной раковине. Средой обитания этого микроба является воздух, вода, почва и микрофлора человека.
Этот микроорганизм имеет правильную округлую форму и является условно-патогенным агентом.
Его присутствие в обычном состоянии на кожных покровах человека не представляет опасности для организма, но при определенных условиях может спровоцировать развитие серьезных патологий.
Основной причиной развития стафилококковой инфекции является ослабление иммунной системы человека. Влияние на этот процесс оказывают следующие факторы:
- Наличие хронических недугов.
- Длительный прием антибиотиков и иммунодепрессантов.
- Нехватка витаминов.
- Простудные и вирусные заболевания.
- Постоянные стрессовые ситуации.
Инфицирование стафилококком может произойти в любом возрасте, но особенно этому подвержены пожилые люди и дети.
Пути заражения стафилококковой инфекцией
Проникновение бактерий в слуховой орган в основном происходит через небольшие ранки и трещины, которые находятся в полости уха.
https://youtube.com/watch?v=2vhiQMfwr40
Патогенные микроорганизмы попадают внутрь вместе с грязными руками и вызывают воспалительный процесс. Часто на фоне активизации микробов поражается наружная часть ушной раковины, но возможно развитие воспаления и в среднем отделе уха.
Такое распространение микробов приводит к возникновению такого заболевания, как гнойный отит.
Заражение золотистым стафилококком происходит следующими способами:
- Воздушно-капельным путем, когда инфекция попадает после тесного контакта с больным человеком.
- При несоблюдении гигиенических процедур в ушной раковине. В этом случае создаются благоприятные условия для активизации и роста микробов.
- После проведения инъекций, хирургических вмешательств в условиях стационара с недостаточной санитарной обработкой.
- Употребление мясных и молочных продуктов, зараженных стафилококком.
- После инфицирования патогенными микроорганизмами полости уха возникают определенные симптомы, при обнаружении которых необходимо сразу обратиться к врачу.
- Несвоевременное обращение к доктору и отсутствие лечения могут вызвать опасные осложнения, к которым относят частичную или полную потерю слуха, воспаление легких, мастоидит, менингит, остеомиелит и стафилококковый сепсис.
- Наличие стафилококковой инфекции в органах слуха может вызывать следующую симптоматику:
- Острая боль при надавливании на козелок.
- Отечность и заложенность слухового прохода.
- Зудящие ощущения.
- Повышение температуры тела.
- Общая слабость.
- Выделения из уха в виде слизи зеленого цвета и гноя.
- Появление корочек в ушной раковине.
- Повреждения кожных покровов в области ушей.
Стафилококк в ухе: проявления, осложнения, лечение — Все микробы
В воздухе и на земле широко распространена такая бактерия, как стафилококк. Они часто встречаются в организме людей и животных. Выделяют несколько видов инфекции, среди которых есть как безвредные, так и особо опасные вирусы для жизнедеятельности человека.
Среди них отмечают стафилококк гемолитический, вызывающий гнойные воспаления; сапрофитный, разрушающий мочевую систему; эпидермальный, негативно действующий на кожный покров. Но самым опасным для человека считается золотистый. Он окрашивает ухо в золотистый оттенок и сильно влияет на общее состояние человека.
Таким образом, стафилококк может вызвать серьезные заболевания. Например, в среднем ухе или воспаление евстахиевой трубы.
- Помимо этого, в ухе могут появиться гнойные выделения и образование спаек и корочек.
- Обратите внимание на фото стафилококка в ушах:
- Запущенные виды стафилококка.
Важно заметить симптомы в момент зарождения инфекции. Тогда вы обойдете серьезные последствия и осложнения. Неважно, какое именно у вас поражение уха — золотистый или эпидермальный стафилококк. Меры по излечению необходимо принять очень быстро.
Заметив данные симптомы, обратитесь к ЛОР-врачу для постановления диагноза.
- воспаление мозговых оболочек;
- инфекционное воспаление костной ткани. В том числе заболевание костей и самого костного мозга;
- частичная потеря слуха или ;
- воспаление легких.
Перед тем как начать лечение, необходимо обратиться к квалифицированному специалисту. Он осмотрит ухо и назначит необходимое лечение. Терапия должна быть комплексной и включать в себя как лекарственные препараты, так и местные способы. Итак, чем лечить стафилококк в ухе?
Используйте перечисленные средства в соответствии с инструкцией и с применением . Так лекарство будет действовать более эффективно.
Курс лечения не должен превышать 12-14 дней.
Если на протяжении всего курса лечения у пациента повышенная температура, принимайте . А также разрешается применение согревающих компрессов.
- Обратите внимание, если после применения антибиотиков больному не стало лучше, необходимо сделать
Очень многие люди интересуются вопросом, передается ли стафилококк воздушно-капельным путем?
Следите за стерильностью материалов при перевязках или использовании медицинских инструментов, так как инфекция может перенестись и через них.
Тщательно мойте овощи и фрукты.
Большая вероятность попадания инфекции при чихании или кашле.
Часто его встречают на медицинских инструментах, предметах быта и даже детских игрушках.
Чаще всего золотистый стафилококк встречается у детей, реже – у взрослых.
- Долгое применение антибиотиков.
- Сильные стрессы.
- Употребление большого количества сладкого, жирного и мучного.
- Нехватка витаминов.
- Изменение состава микроорганизмов в кишечнике.
- Отсутствие гигиены.
- трещинки на соске матери;
- кормление ребенка искусственными смесями;
- позднее прикладывание малыша к груди.
Симптомы появления заболевания различны. К основным критериям относятся:
- отек пупочного кольца;
- переполнение кровью сосудов кровеносной системы рядом с пупком.
https://youtube.com/watch?v=ARu6i7bxOWY
Интересно, что препарат после применения действует на протяжении шести часов.
Препарат обладает антимикробным действием и весьма эффективен при лечении данного воспаления.
Известно, что золотистый стафилококк вылечить намного тяжелее, чем другие виды данного воспаления. Важно проследить за тем, чтобы принимаемые антибиотики не вызвали привыкания. После курса лечения важно поддержать иммунитет курсом витаминов и восстановительных медикаментов.
При разрешении специалиста, больной может воспользоваться средствами местного действия. В них входят принятие отваров, применение перекиси водорода и других раствором.
Поместите отвар в темное место на несколько часов. Затем отожмите сырье и процедите. Закапывайте настойку в каждое ухо по три капли в течение недели.
Стафилококк, в особенности золотистый, нельзя оставлять без внимания. Он может принести множество дополнительных заболеваний, а также заметно снизить слух человека.
Для его излечения требуется много времени и стараний. Опытный врач, осмотрев уши, назначит индивидуальное лечение стафилококка в ухе, способное как можно быстрее вернуть здоровье пациенту.
Важно заниматься профилактикой заболевания.
В него входит укрепление организма путем закаливания и здорового образа жизни. Следите за питанием и внимательно относитесь к правилам гигиены.
Задать свой вопрос
Вопросы и ответы по: стафилококк в ухе лечение
2016-07-03 05:44:31
Здравствуйте! Три месяца назад был отит правого уха, анализ мазка показал золотистый стафилококк. Три недели лечения. Затем повторный анализ на микрофлору и чувствительность к бактериофгам, на этот раз Staphylococcus epidermidis 10*4. Через неделю у меня плановое кесарево сечение. Подскажите насколько вреден данный вид стафилококка для меня и ребенка. Спасибо!
Стафилококк всегда был вреден для здоровья, но для борьбы с ним у человека есть иммунитет. Поэтому часто определяется носительство стафилококка. Иммунитет у ребёнка — это грудное вскармливание и гигиена.
2014-02-20 11:47:18
В октябре 2013 обратилась к ЛОРу — зуд в ухе.Посев показал наличие грибов и стафилококка эпидермального. Прошла лечение антибиотик клацид в уши нитрофунгин 21 день. На время зуд не так беспокоил.
В феврале 2014 посев из ушей показал стафилококк золотистый умеренный рост, причем когда брали мазок с ухо то через 15-20 минут я обнаружила кровь в ухе вероятно при заборе вскрылась какая-то микроранка.
Теперь я переживаю если обнаружили стафилококк золотистый в ухе то не мог ли из уха стафилококк попасть в кровь. Как лечить стафилококк в ушах. Врач сказал капать в ухо ципролет 3 раза в день и УФО семь раз.
Другой врач предложила пропить антибиотики из ряда чувствительных из анализа на посев. Я отказалась. И может ли за 5 месяцев наблюдаться такое разнообразие стафилококков да еще и грибы. Лейкоцитов в крови 3,6 ниже нормы.
Стафилококк в ушах: как проявляется и как от него избавиться?

Здоровый организм и сильный иммунитет не дает бактериям размножаться и вызывать инфекционные заболевания.
Стафилококк находится в организме каждого второго человека, но начинает себя проявлять только при наличии благоприятных факторов, вызывающих ослабление организма.
Именно поэтому его наиболее часто выявляют у детей раннего возраста, у которых еще не полностью сформирована иммунная система и высокая чувствительность ко всем патогенным микроорганизмам.
Боль в ухе как симптом стафилококка
Среди всех видов стафилококка следует выделить золотистый – такое название он получил из-за своего желто-золотистого цвета. Его клетки шаровидной формы и размером 0,6-1,2 мкм. Оптимальная температура для размножения от 30 до 38°С, а жизнедеятельность сохраняется при температурах от 4 до 43°С, но они способны адаптироваться и выживать при более суровых условиях.
Внимание! Только этот вид бактериальных микроорганизмов способен сохраняться в солевых растворах и заражать консервы.
Золотистый стафилококк в ушах – очень частое явление, возникающее, как осложнение инфекций носоглотки. Его особенность в том, что каждая клетка выделяет большое количество токсинов, накапливающихся в организме и вызывающих тяжелые последствия.
Причины возникновения стафилококка в ушах
Передается ли стафилококк от человека к человеку, можно понять, если выделить основные пути инфицирования:
- воздушно-капельный – по воздуху после кашля или чихания;
- контактный – при рукопожатии, объятиях, поцелуях;
- бытовой – через общие предметы гигиены, одежду, посуду;
- операционный – заражение происходит во время или после хирургического вмешательства.
Итак, носителем инфекции является зараженный человек. Он способен инфицировать любого, кто близко с ним общается, постельное белье, бытовые предметы. Но у людей с сильным иммунитетом клетки бактерий нейтрализуются и прекращают свою жизнедеятельность.
Стафилококк в ухе
Благоприятные факторы для проникновения инфекции:
- сбои в работе иммунной системы;
- иммунодефицитные заболевания (ВИЧ, СПИД);
- аутоиммунные патологии;
- нарушение циркуляции крови;
- онкологические опухоли;
- сильное переохлаждение;
- хронические заболевания ушей и внутренних органов;
- эндокринные нарушения;
- длительное течение простудных и вирусных болезней;
- несоблюдение правил гигиены;
- наличие вредных привычек;
- неблагоприятные бытовые условия;
- плохая окружающая среда.
Очень часто обнаруживается стафилококк у новорожденных детей. Он поражает только что родившегося ребенка еще в роддоме, если там не придерживаются норм санитарии. Грудничек еще не может сопротивляться атаке микроорганизмов, так как у него еще только начинает устанавливаться иммунная система. Любая царапина или несоблюдение гигиены способствуют быстрому развитию болезни.
Основная причина, почему появляется стафилококк в ушах – нарушение целостности кожного покрова или слизистых оболочек органов слуха. Царапины, расчесы, гематомы оперативные вмешательства – все это может привести к стремительному размножению бактерий.
Заболевания слуховых органов, способствующие присоединению инфекции:
Но, даже при сохранении целостности кожных покровов, золотистый стафилококк проникает в ухо из носоглотки и нижних дыхательных путей. Причиной становятся бактериальные заболевания: гайморит, ангина, бронхит, пневмония. Патогенные микроорганизмы могут переноситься вместе с кровью и лимфатической жидкостью из любых других органов, в которых имеются инфекционные очаги.
Симптомы и проявление стафилококка в ушах
Наиболее частое проявление стафилококка в ухе – гнойный отит, поэтому все симптомы аналогичны воспалению наружного или среднего уха. Первые клинические признаки – боль и отечность слухового прохода.
Через некоторое время появляются гнойные выделения, тугоухость, посторонние шумы.
При прогрессировании процесса возникают симптомы стафилококка в ухе, вызванные интоксикацией: повышение температуры, лихорадка, общая слабость.
У ребенка воспалительный процесс развивается быстрее и протекает гораздо тяжелее, чем у взрослых. Грудные дети не могут пожаловаться на боль, но повышенная капризность или вялость, отсутствие аппетита и нарушение сна должны насторожить родителей.
При проникновении золотистого стафилококка в ухо, симптомы становятся более выраженными и очень быстро прогрессируют. Уже на первых этапах развития болезни, пациент начинает чувствовать себя очень плохо, из-за выделяемых микроорганизмами токсинов.
Можно выделить общие симптомы стафилококка в ушах:
- болезненность, усиливающаяся при пальпации;
- повышение температуры кожи в области очага;
- гиперемия и отечность;
- заметное расширение сосудов;
- формирование гнойников, выделение гноя;
- ухудшение слышимости, если поражен слуховой проход;
- лихорадка, озноб;
- повышенная температура;
- общая слабость.
Признаки стафилококка в ушах могут выражаться формированием фурункулов в области ушной раковины. Фурункулы – это гнойники, заполненные гнойно-некротическими массами, которые, если их не лечить, вызывают развитие фурункулеза, трудно поддающегося лечению.
Методы диагностики и выявления стафилококка
Очень важно не упустить первые симптомы воспалительного процесса и не допустить его распространения по всему организму, поэтому при первых подозрительных признаках необходимо посетить отоларинголога.
Диагностика стафилококка в ухе преследует три цели:
- выявление вида бактерий (золотистый, эпидермальный, сапрофитный);
- определение локализации очага;
- установление чувствительности и резистентности к антибиотикам.
Для опытного ЛОР-врача диагностика не представляет сложностей. С помощью визуального осмотра и отоскопии врач определяет локализацию инфекционного очага и степень поражения тканей. Обязательно учитывается анамнез больного, чтобы определить, как появился стафилококк в ухе.
Чтобы определить вид микроорганизмов и их чувствительность к антибактериальным препаратам, исследуют биологический материал, взятый со слизистых оболочек или кожных покровов. Если кроме поражения уха, наблюдается воспаление носоглотки, то соскоб берут из горла и носовых ходов – это поможет определить, где самый сильный воспалительный процесс.
Если не удается определить вид возбудителя, то используют серологический метод исследования крови, позволяющий выявить наличие антител к стафилококку. Как правило, этот метод необходим при хроническом течении болезни.
Другие необходимые анализы:
- Общий и биохимический анализ крови.
- Общий анализ мочи.
- Иммунограмма.
При стафилококке в ушах, диагностика должна быть полной и качественной. Любая врачебная ошибка может привести к тяжелому течению болезни и распространению инфекции по черепной коробке и другим тканям организма.
Лечение стафилококка в ушах
Способ терапии определяется локализацией воспалительного процесса. Если поражено только наружное ухо, то используют средства для местного использования. При поражении внутренних структур или неэффективности наружных средств, необходимо подключать препараты системного действия.
Препараты для местного лечения стафилококка в ушах:
- Мази: Гентамициновая, Метилурациловая, Фузидерм, Левомеколь, Фуцидин.
- Капли: Дексона, Полидекса, Нормакс, Ципромед, Анауран.
При сильной отечности назначают кортикостероидные средства для аппликаций или введения в слуховой проход с помощью ватных турунд: Дексаметазон, Гидрокортизон, Бетаметазон.
Системное лечение стафилококка в ушах наиболее эффективно, если был проведен анализ на чувствительность бактерий к препаратам. Но при плохом самочувствии пациента результатов не дожидаются, и назначают антибиотики широкого спектра действия:
- Кларитромицин.
- Азитромицин.
- Ципрофлоксацин.
- Амоксициллин.
Если анализы выявляют резистентные штаммы, то нужен прием таких мощных препаратов, как Левофлоксацин или Рокситромицин. Эти средства назначают только после получения результатов бактериологического исследования.
Иногда результаты определяют, что стафилококк в ухе чувствителен к сульфаниламидам. Среди эффективных препаратов выделяют: Сульфазин, Сульфадиметоксин, Этазол.
Для снижения температуры и уменьшения головных болей назначают лекарства с жаропонижающим и обезболивающим действием: Нурофен, Парацетамол, Ибупрофен, Кеторолак.
Народные методы
Лечить стафилококк в ухе народными методами можно, только если поражена ушная раковина. При инфицировании среднего и внутреннего отдела слухового аппарата необходимо обратиться к традиционной терапии.
Чем можно лечить:
- В 100 мл. теплой кипяченой воды развести 2 ст. ложки яблочного уксуса. Смочить в растворе сложенную в несколько раз марлю и прикладывать к пораженной области 2 раза в день на 15 минут.
- Заварить 4 ст. ложки окопника в стакане кипятка. После остывания процедить и использовать для компрессов дважды в день.
- Прикладывать разрезанный лист алоэ, закреплять повязкой или пластырем. Повторять 2-3 раза в сутки.
- Головку чеснока измельчить и настоять в 150 мл. воды. После процеживания, полученный настой, использовать для компрессов.
Стафилококк в ухе пройдет быстрее, если укреплять иммунитет. Во время болезни нужно употреблять больше витамина С, которого много содержится в клюкве, смородине, шиповнике и зелени. Полезно принимать отвар эхинацеи, листьев черной смородины или настойку прополиса.
Как уберечься от рецидива болезни?
Даже правильно назначенное лечение не всегда позволяет полностью избавиться от золотистого стафилококка в ухе. Выжившие клетки остаются на кожных покровах и слизистых оболочках и при малейшем снижении иммунитета начинают активироваться.
Очень трудно предупредить рецидив, особенно у ребенка раннего возраста, из-за опасности длительного применения антибиотиков. Поэтому главные меры профилактики рецидива заключаются в укреплении иммунной системы, своевременном пролечивании болезней ушей и носоглотки, правильной обработке поврежденной кожи.
Если болезнь возвращается, а диагноз повторяется — это значит, что стафилококк в ухе перешёл в хроническую форму.
Попытаться полностью избавиться от бактерий поможет только бактериофаг – лекарство, содержащие вирусы, уничтожающие только клетки определенных бактерий.
Внимание! Нельзя использовать бактериофаги при тяжелом течении болезни, сопровождающейся признаками интоксикации. В этом случае могут помочь только антибиотики.
Осложнения и последствия стафилококка в ушах
Своевременная терапия и правильно подобранные препараты – залог предотвращения осложнений. Но, если не лечить стафилококк, то возникают, неблагоприятные для здоровья и жизни, последствия.
Стафилококк в ушах, способен очень быстро распространиться по соседним тканям и вызвать такие заболевания, как мирингит, мастоидит и евстахиит. Если инфекция проникнет в дыхательные пути, то возникает гайморит, гнойная ангина, бронхит или пневмония.
Самое опасное осложнение стафилококка в ушах – менингит. Резкое ухудшение состояние, сопровождающееся ознобом, спутанностью сознания, рвотой и судорогами – говорит о воспалении оболочек мозга. Такое состояние требует экстренной госпитализации, иначе могут остаться необратимые последствия: судорожные припадки, когнитивные расстройства, слабоумие.
Другие последствия стафилококка в ухе:
- снижение или полная потеря слуха;
- остеомиелит;
- поражение внутренних органов;
- заражение крови.
При длительном воспалении ушной раковины, развивается перихондрит, сопровождающийся некротическим процессом и расплавлением хрящевых тканей. Если своевременно не начать терапию, то происходит деформация раковины.
Прогноз
Если начать терапию при первых проявлениях, то прогноз стафилококка в ушах благоприятный. Большинство пациентов полностью забывают о болезни уже через несколько недель.
Прогноз неблагоприятен в следующих случаях: сильно ослабленный организм, поздняя диагностика, неправильно подобранные антибиотики. Эти факторы приводят к затяжному лечению или переходу инфекции в хроническую форму.
Профилактика возникновения стафилококка в ушах
Предупредить инфицирование можно с помощью профилактических мер, которые защитят и от других заболеваний.
Профилактика поражения уха стафилококком:
- Принимать витамины, закаливаться;
- использовать только личные предметы гигиены;
- предупреждать формирование серных пробок;
- избегать контактов с зараженными людьми;
- часто мыть руки;
- обрабатывать антисептиками раны, укусы, царапины;
- тщательно лечить инфекции ЛОР-органов.
Стафилококк в ушах требует регулярной смены постельного белья и полотенец. Лучше, если больной человек будет спать на отдельной постели и регулярно мыть руки, чтобы не заразить своих родных.
Стафилококк за ушами

Стафилококк в ушах, носоглотке или на поверхности кожи человека – обычное явление. Это грамположительная неподвижная бактерия, имеющая правильную круглую или овальную форму. По данным исследований, ее носителями является более 70% населения, однако она вызывает серьезные заболевания только тогда, когда для этого создаются необходимые условия (то есть, является условно-патогенной).
статьи
Причины появления
Золотистый стафилококк в ухе селится на кожных покровах, как у детей, так и у взрослых.
Однако у детей он проявляется гораздо чаще из-за большей подверженности организма действию патогенной микрофлоры и несоблюдения правил личной гигиены.
Самыми известными проявлениями бактерии являются кожные гнойники: фурункулы, карбункулы, ячмени. Попадая внутрь органа слуха, она способна привести к развитию острого гнойного отита.
Чаще всего причиной активизации золотистого стафилококка в ухе – это микроскопические повреждения кожи, через которые патоген проникает в организм.
Передается он различными путями: контактным и воздушно-капельным, в наружную часть слухового органа обычно проникает при помощи немытых рук. Способствовать началу болезни может ряд факторов:
- ослабленный иммунитет в связи с применением иммунодепрессантов и антибиотиков, а также сезонное снижение защитной функции организма по причине гиповитаминоза;
- хронические недуги (болезни щитовидной железы, сахарный диабет, другие аутоиммунные заболевания);
- неблагоприятные условия окружающей среды, в т.ч. экологический фактор.
Симптомы
При наличии стафилококка в ухе (или ушах) симптомы являются главным аргументом для обращения к отоларингологу:
- отек, чувство заложенности и необычный шум в голове;
- боль и зуд в наружном слуховом проходе, особенно при нажимании на козелок;
- наличие внутри слухового канала слизи зеленоватого цвета с неприятным запахом, а затем гноя;
- образование корочек;
- повреждения кожного покрова;
- общая слабость и повышение температуры.
При этом пораженная зона приобретает золотистый оттенок.
Если есть обоснованные подозрения, что активизировался золотистый стафилококк в ухе, лечение нужно проводить быстро во избежание серьезных осложнений:
- пневмонии (воспаления легких);
- снижения слуха вплоть до полной его потери;
- мастоидита;
- воспалений головного или костного мозга (менингита или остеомиелита);
- стафилококкового сепсиса, охватывающего все системы человеческого организма.
Диагностика и лечение
Устанавливать диагноз болезни должен врач-отоларинголог на основании изучения клинической картины и опроса больного. Специалист точно определит место локализации патогенной микрофлоры и разработает адекватную схему лечения. Ошибка в постановке диагноза может сделать терапию неэффективной и привести к осложнениям.
Лечение стафилококка в ушах осложняется его устойчивостью ко многим лекарственным средствам и активным веществам. Бактерия сохраняет активность в обезвоженном состоянии, не боится прямых солнечных лучей и высоких температур.
Она устойчива к этиловому спирту, а перекись водорода способна при помощи особого фермента каталазы перерабатывать и усваивать. Кроме того, используя фермент коагулазу, бактерия проникает с кожи в сосуды и сворачивает кровь, что грозит сепсисом и быстрым перемещением инфекции по всему организму с образованием гнойников.
При попадании через слизистые оболочки носоглотки в легкие она способна вызывать трудноизлечимую пневмонию.
При кипячении бактерия мгновенно погибает. Также, несмотря на устойчивость к отдельным антибиотикам, она боится анилиновых красителей. Поэтому вовремя обработанный обычной зеленкой (раствором бриллиантового зеленого) порез – достаточно надежный барьер на пути проникновения инфекции.
В зависимости участка, где расположился золотистый стафилококк в ушах, лечение может быть местным или общим.
- Местная терапия применяется при наружном отите. Прописываются мази и капли, содержащие в составе поликсин, неомицин, колистин или же кортикостероиды. Капать препараты непосредственно в слуховой канал не рекомендуется, лучше смочить лекарством ватную или марлевую турунду и осторожно ввести в ушной проход. Повторять процедуру следует не менее 3-4 раз в день.
Если боль не проходит, можно использовать сухое тепло, обезболивающие таблетки и кварцевание. Хорошо зарекомендовала себя гентамициновая мазь, которой в течение недели обрабатывают наружные слуховые каналы.
- Общая терапия показана при среднем отите.
Назначаются антибиотики, чаще всего ампициллин (на 10 дней по 50-100 мг 4 раза в сутки), жаропонижающие и обезболивающие препараты. Рекомендуются согревающие компрессы на слуховой орган. В случае отсутствия улучшений через двое суток, врач может произвести тимпанопункцию или тимпаноцентез, заключающийся в проколе барабанной перепонки.
Эта процедура освобождает полости от экссудата, при этом также берется проба жидкости на устойчивость к антибиотикам для коррекции курса терапии.
Для надлежащей эффективности антибиотикотерапии необходимо сначала пройти проверку на устойчивость бактерии к тем или иным антибиотикам. Нельзя делать перерывы во время курса антибиотиков или преждевременно прекращать его, ориентируясь на улучшение своего самочувствия. Это может привести к адаптации бактерии к действию данного препарата.
Средства народной медицины
Лечение золотистого стафилококка средствами народной медицины может быть достаточно эффективным, но в любом случае оно должно носить вспомогательный характер по отношению к традиционному лечению. Содержащиеся в растениях активные вещества угнетают патогенные микроорганизмы, снимают боль и воспаление, дезинфицируют пораженный участок и повышают иммунитет.
Несколько советов применения народных средств:
- Зверобой. Настоем или отваром зверобоя промывается предварительно очищенный от серы проход для уменьшения воспаления. Рационально это делать незадолго до приема основного лекарства. Зверобой – сильный природный антибиотик и хорош для местного применения.
- Раствор диоксидина. 4 капли раствора капают в слуховой канал, через 10-15 минут высушивают его ватной палочкой. Процедура повторяется дважды в день (с утра и вечером).
- Отвары ромашки, календулы, шалфея хорошо поддерживают классическую терапию. Нужно только обращать внимание на то, что некоторые травы могут вызывать у людей аллергическую реакцию. Отвар должен быть приблизительно температуры тела человека, более холодная жидкость приведет к сужению сосудов и ослаблению действия лекарства.
Уменьшить вероятность заболевания бактериальной инфекцией можно, используя простые правила:
- занятия физкультурой и здоровый образ жизни;
- правильное и полноценное питание;
- соблюдение правил личной гигиены и чистоты в жилище;
- своевременное устранение заболеваний зубов и носоглотки.
Стафилококк – одна из самых опасных бактерий, которая может поразить любой орган, быстро распространиться по всему организму и вызвать тяжелые последствия. Стафилококк в ушах это не редкость и чаще всего его обнаруживают у детей раннего возраста.






